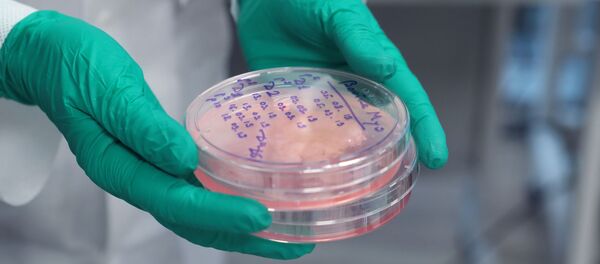
Obrazes kultiviruyemogo masa, virashennogo v laboratorii gennoy injenerii v Ochakovskom kombinate pishevix ingrediyentov (OKPI) v Moskve. - Sputnik O‘zbekiston

TOShKENT, 4 dek - Sputnik. Microsoft kompaniyasi asoschisi, Bill Geyts 16-yil davomida dunyoning eng boy odami bo‘lgan. Bugungi kunda uning boyligi 96,5 milliard dollarga baholanmoqda.
Xo‘sh shunday badavlat odam har kuni qanday ovqatlar tanovul qiladi deb o‘ylaysiz? Balkim uning diyetasi faqat qora ikra, lobster va shampan vinosidan iboratdir?
Aslida unday emas, deb yozadi Rossiyaning "Gastronom’" nashri. Yaqinda Bill Geyts haqida chiqqan kichik hujjatli filmda aytilishiga ko‘ra, uning sevimli ovqati bu – gamburger. Shuningdek u mol go‘shtidan tayyorlangan ovqatlarni xush ko‘rishi aytilgan. Ha aymoqchi u hech qachon nonushta qilmas ekan. Kun davomida Geyts bir necha marotaba yong‘oq iste’mol qilar va juda ko‘p kofe ichar ekan.
Shuningdek, bugungi kunda Bill Geyts oziq ovqat sohasida yangi biznesga asos solgan. U amerikada Beyond Meat nomli kompaniyaga pul tikkan. Ushbu kompaniya laboratoriya sharoitida go‘sht yaratish bilan shug‘ullanadi. Sun’iy go‘sht nuxat oqsili va raps yog‘idan tayyorlanadi. Laboratoriya go‘shti hidi, ta’mi va ko‘rinishidan haqiqiy go‘shtga o‘xshaydi. Bugungi kunda u dunyoning turli mamlakatlarida sotilmoqda, lekin uning narxi eng qimmat “marmar mol go‘shti” bilan teng, deyilgan xabarda.